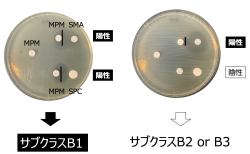

マイストア
変更
お店で受け取る
(送料無料)
配送する
納期目安:
2025.09.12 7:43頃のお届け予定です。
決済方法が、クレジット、代金引換の場合に限ります。その他の決済方法の場合はこちらをご確認ください。
※土・日・祝日の注文の場合や在庫状況によって、商品のお届けにお時間をいただく場合がございます。
感染制御学 医療科学部 臨床教育連携ユニット 感染制御学分野 | 藤田医科の詳細情報
医療科学部 臨床教育連携ユニット 感染制御学分野 | 藤田医科。医療科学部 臨床教育連携ユニット 感染制御学分野 | 藤田医科。医療科学部 臨床教育連携ユニット 感染制御学分野 | 藤田医科。
商品説明
「感染制御学」
北里大学感染制御研究機構 – ワンヘルスの向上、感染症の制圧を
β‐ラクタム系薬/上田泰,清水喜八郎【共編】
児玉典子
新臨床眼科全書(9-A) 水晶体 硝子体/市川宏(編者)
乳がん標準化学療法の実際 認定看護師制度とがん専門薬剤師認定制度の導入を含め/金原出版/佐伯俊昭(単行本)
こちらの商品は現役6年制薬学生が使用していた製品になります。終末期医療のエビデンス/ステファン・J.マクフィー(著者),日経メディカル(編者)。)
ビギナ-からエキスパ-トまでのホルタ-心電図パ-フェクト /中山書店/井上博(循環器内科学)(単行本)
漢方用語大辞典
ちなみにこの参考書を使用して6年間フル単で乗り切りました。サイコネフロロジ-の臨床 透析患者のこころを受けとめる・支える /メディカ出版/春木繁一(単行本)。
ナ-スのための手術介助アトラス /金原出版/及川隆司(単行本)
古代出雲の薬草文化 見直される出雲薬と和方 新版/出帆新社/横浜薬科大学漢方和漢薬調査研究センタ-(単行本)
所々付箋や、マーキング等ございますのでご了承ください。(勉強の参考にしていただけると幸いです。レジデントのための感染症診療マニュアル 第4版/医学書院/青木眞(単行本)。リウマチ学用語集 改訂第2版増補/南江堂/日本リウマチ学会(ペーパーバック)。
●01)【同梱不可】心房細動の外科的治療/Surgical Treatment of Atrial Fibrillation/Jonathan Philpott/Academic Press/洋書/医学/医療/A
麻酔科医のための周術期の疼痛管理 /中山書店/川真田樹人(単行本)
#薬学部
薬学の歴史くすり・軟膏・毒物 /薬事日報社/アクセル・カーン(単行本)
#薬学生
カレントレビュー 心血管インターベンション メディカルトリビューンブックス/Eric J.Topol(著者),Patric W.Serruys(著者),延吉正清(訳者)
#薬科大学
対策型検診のための胃内視鏡検診マニュアル/南江堂/日本消化器がん検診学会対策型検診のための(大型本)
杉山真伝流臨床指南 /六然社/大浦慈観(単行本)
#児玉典子
人工股関節全置換術「THA」のすべて 改訂第2版/メジカルビュ-社/伊藤浩(単行本)
#エンタメ/ホビー
スピリチュアル・マテリア・メディカ 第2巻 ★英語版★
#本
看護で教える最新の口腔ケア 授業・演習、臨床・在宅現場でも、すぐに使える!/大道学館出版部/水田祥代(大型本)
#健康/医学
症状別・病態別精神科看護 事例で展開しているからわかりやすい/日総研出版/平澤久一(単行本)
#BOOK
新臨床眼科全書(8-A) 網膜疾患 1/市川宏(編者)
北里大学感染制御研究機構 – ワンヘルスの向上、感染症の制圧を
β‐ラクタム系薬/上田泰,清水喜八郎【共編】
児玉典子
新臨床眼科全書(9-A) 水晶体 硝子体/市川宏(編者)
乳がん標準化学療法の実際 認定看護師制度とがん専門薬剤師認定制度の導入を含め/金原出版/佐伯俊昭(単行本)
こちらの商品は現役6年制薬学生が使用していた製品になります。終末期医療のエビデンス/ステファン・J.マクフィー(著者),日経メディカル(編者)。)
ビギナ-からエキスパ-トまでのホルタ-心電図パ-フェクト /中山書店/井上博(循環器内科学)(単行本)
漢方用語大辞典
ちなみにこの参考書を使用して6年間フル単で乗り切りました。サイコネフロロジ-の臨床 透析患者のこころを受けとめる・支える /メディカ出版/春木繁一(単行本)。
ナ-スのための手術介助アトラス /金原出版/及川隆司(単行本)
古代出雲の薬草文化 見直される出雲薬と和方 新版/出帆新社/横浜薬科大学漢方和漢薬調査研究センタ-(単行本)
所々付箋や、マーキング等ございますのでご了承ください。(勉強の参考にしていただけると幸いです。レジデントのための感染症診療マニュアル 第4版/医学書院/青木眞(単行本)。リウマチ学用語集 改訂第2版増補/南江堂/日本リウマチ学会(ペーパーバック)。
●01)【同梱不可】心房細動の外科的治療/Surgical Treatment of Atrial Fibrillation/Jonathan Philpott/Academic Press/洋書/医学/医療/A
麻酔科医のための周術期の疼痛管理 /中山書店/川真田樹人(単行本)
#薬学部
薬学の歴史くすり・軟膏・毒物 /薬事日報社/アクセル・カーン(単行本)
#薬学生
カレントレビュー 心血管インターベンション メディカルトリビューンブックス/Eric J.Topol(著者),Patric W.Serruys(著者),延吉正清(訳者)
#薬科大学
対策型検診のための胃内視鏡検診マニュアル/南江堂/日本消化器がん検診学会対策型検診のための(大型本)
杉山真伝流臨床指南 /六然社/大浦慈観(単行本)
#児玉典子
人工股関節全置換術「THA」のすべて 改訂第2版/メジカルビュ-社/伊藤浩(単行本)
#エンタメ/ホビー
スピリチュアル・マテリア・メディカ 第2巻 ★英語版★
#本
看護で教える最新の口腔ケア 授業・演習、臨床・在宅現場でも、すぐに使える!/大道学館出版部/水田祥代(大型本)
#健康/医学
症状別・病態別精神科看護 事例で展開しているからわかりやすい/日総研出版/平澤久一(単行本)
#BOOK
新臨床眼科全書(8-A) 網膜疾患 1/市川宏(編者)
商品情報
ベストセラーランキングです
近くの売り場の商品
カスタマーレビュー
オススメ度 4.2点
現在、2942件のレビューが投稿されています。